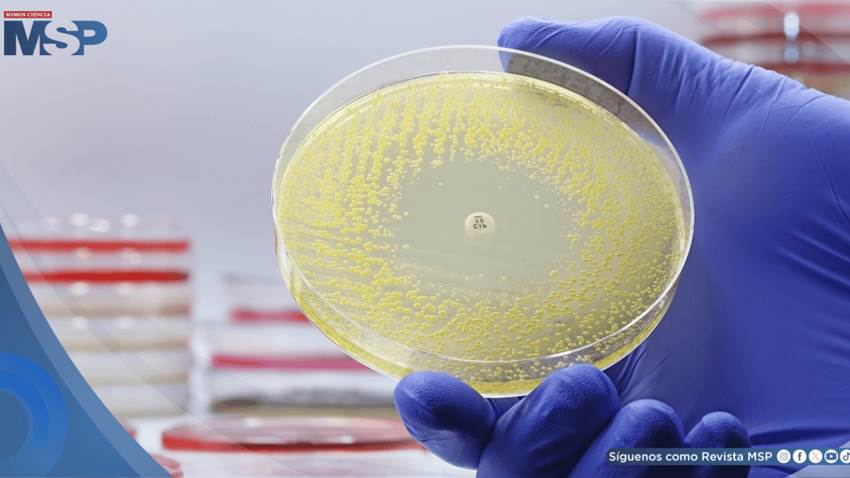

La resistencia bacteriana a los antibióticos es una de las mayores amenazas de salud pública a nivel mundial. Frente a este desafío, un equipo de investigadores de la Universidad de Pensilvania, liderado por el bioingeniero español César de la Fuente, ha diseñado antibióticos inéditos utilizando inteligencia artificial generativa (GenAI).
El hallazgo, publicado en Cell Biomaterials, presenta a AMP-Diffusion, una herramienta capaz de crear moléculas antimicrobianas desde cero, con resultados comparables a fármacos actualmente aprobados y sin efectos adversos en modelos animales.
Noticias relacionadas
Fármaco contra el cáncer de cabeza y cuello en gatos mejora 35% de casos y apunta a terapias humanas
Órganos fantasma: Así funciona la bioingeniería que busca acabar con la lista de espera de trasplantes
La IA mejora la detección tumoral, pero debilitaría la habilidad de los médicos para hallarlos solos
IA que diseña lo que la naturaleza nunca produjo
A diferencia de estudios previos en los que la IA se utilizaba para analizar grandes bases de datos y seleccionar candidatos prometedores, AMP-Diffusion da un paso más: generar estructuras moleculares que no existen en la naturaleza, pero que muestran actividad antibacteriana real.
"Es emocionante ver que nuestras moléculas generadas por IA realmente funcionaron", señaló Pranam Chatterjee, coautor del trabajo. "Esto demuestra que la IA generativa puede ayudar a combatir la resistencia a los antibióticos".
Un avance con impacto clínico
El equipo planea perfeccionar esta tecnología para diseñar antibióticos orientados a infecciones específicas y con propiedades farmacológicas mejoradas. Esto abriría la puerta a tratamientos más precisos y efectivos frente a bacterias multirresistentes, que hoy en día representan un reto crítico en hospitales y sistemas de salud.
"En última instancia, nuestro fin es comprimir el tiempo de descubrimiento de antibióticos de años a días", destacó César de la Fuente, quien ha dedicado su carrera a la búsqueda de terapias innovadoras, desde proteínas de origen neandertal hasta microorganismos extremófilos.
Una herramienta para el futuro de la medicina
La promesa de AMP-Diffusion no solo radica en su capacidad para acelerar el proceso de descubrimiento, sino también en su potencial de revolucionar el desarrollo farmacéutico, ofreciendo nuevas armas contra infecciones que ya no responden a los tratamientos convencionales.
Con este avance, la inteligencia artificial generativa se perfila como una aliada indispensable para enfrentar la crisis global de resistencia antimicrobiana y fortalecer la seguridad de los tratamientos antibióticos en el futuro.